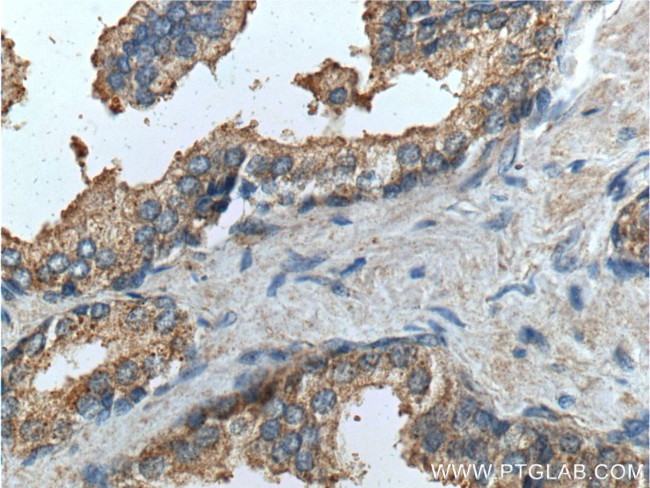
PTGER4 Antibody in Immunohistochemistry (Paraffin) (IHC (P))

Search
Proteintech
PTGER4 Polyclonal Antibody
{{$productOrderCtrl.translations['antibody.pdp.commerceCard.promotion.promotions']}}
{{$productOrderCtrl.translations['antibody.pdp.commerceCard.promotion.viewpromo']}}
{{$productOrderCtrl.translations['antibody.pdp.commerceCard.promotion.promocode']}}: {{promo.promoCode}} {{promo.promoTitle}} {{promo.promoDescription}}. {{$productOrderCtrl.translations['antibody.pdp.commerceCard.promotion.learnmore']}}
产品信息
24895-1-AP
种属反应
已发表种属
宿主/亚型
分类
类型
抗原
偶联物
形式
浓度
规格
纯化类型
保存液
内含物
保存条件
运输条件
产品详细信息
Immunogen sequence: RKTVLSKAI EKIKCLFCRI GGSRRERSGQ HCSDSQRTSS AMSGHSRSFI SRELKEISST SQTLLPDLSL PDLSENGLGG RNLLPGVPGM GLAQEDTTSL RTLRISETSD SSQGQDSESV LLVDEAGGSG RAGPAPKGSS LQVTFPSETL NLSEKCI (333-488 aa encoded by BC101534 )
靶标信息
The protein encoded by this gene is a member of the G-protein coupled receptor family. This protein is one of four receptors identified for prostaglandin E2. This receptor can activate T-cell factor signaling. It has been shown to mediate PGE2 induced expression of early growth response 1, regulate the level and stability of cyclooxygenase-2 mRNA, and lead to the phosphorylation of glycogen synthase kinase-3. Knockout studies in mice suggest that this receptor may be involved in the neonatal adaptation of circulatory system, osteoporosis, as well as initiation of skin immune responses.
仅用于科研。不用于诊断过程。未经明确授权不得转售。
生物信息学
蛋白别名: EP1; G-protein coupled receptor; PTGER4; MGC126583; PGE receptor EP4 subtype; PGE receptor, EP4 subtype; PGE2 receptor EP4 subtype; prostaglandin E receptor 4 (subtype EP4); Prostaglandin E2 receptor EP4 subtype; prostaglandin E2 receptor type 4; Prostanoid EP4 receptor
基因别名: EP4; EP4R; Ptger; PTGER2; PTGER4; Ptgerep4
UniProt ID: (Human) P35408, (Mouse) P32240, (Rat) O08728
Entrez Gene ID: (Human) 5734, (Mouse) 19219, (Rat) 84023